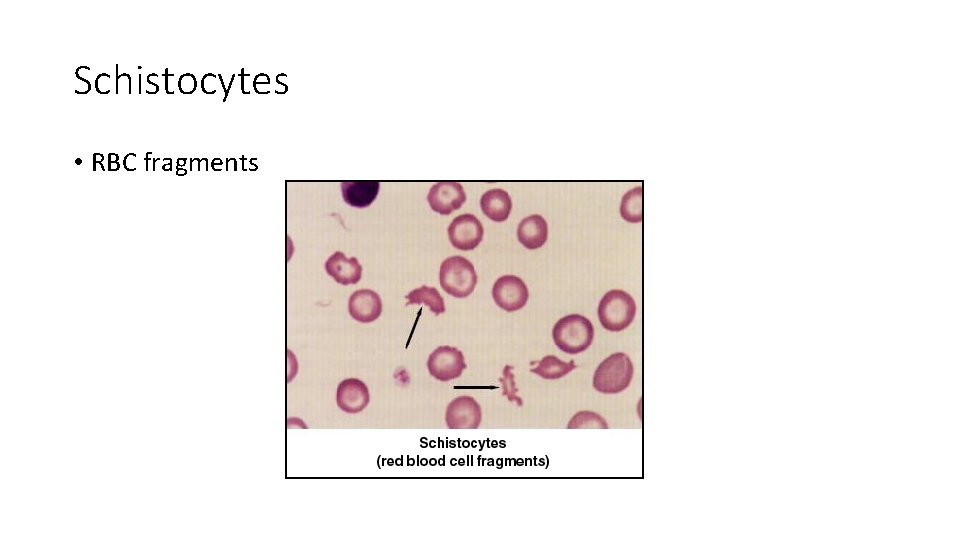
Schistocytes • RBC fragments
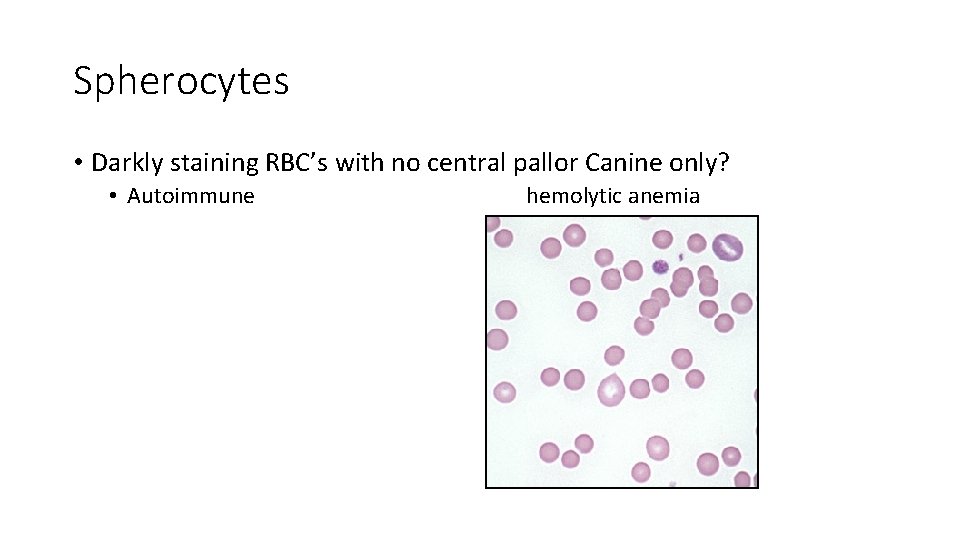
Spherocytes • Darkly staining RBC’s with no central pallor Canine only? • Autoimmune hemolytic
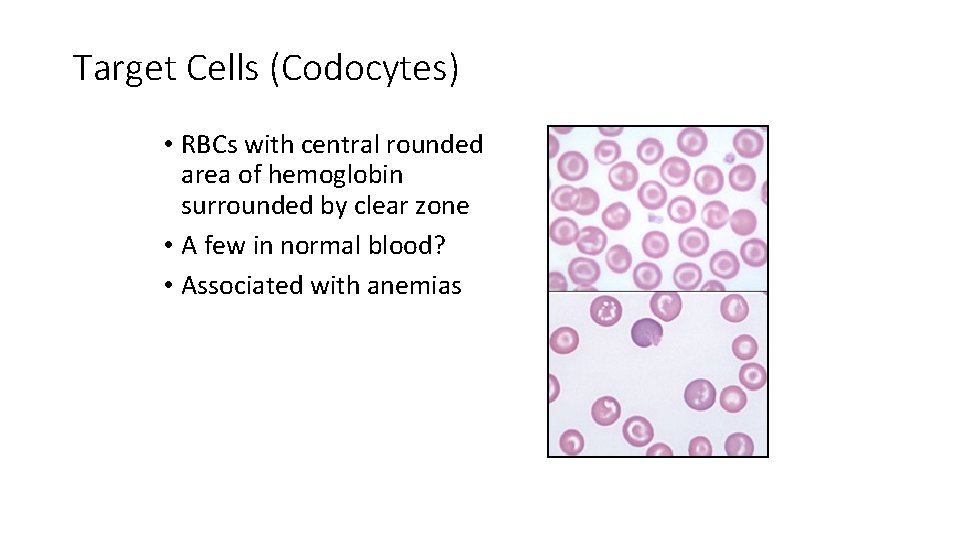
Target Cells (Codocytes) • RBCs with central rounded area of hemoglobin surrounded by clear
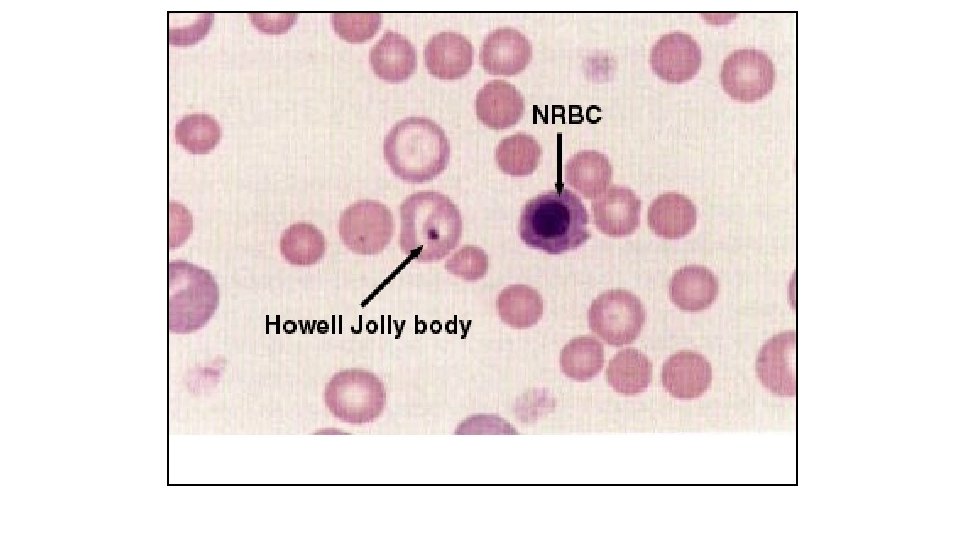
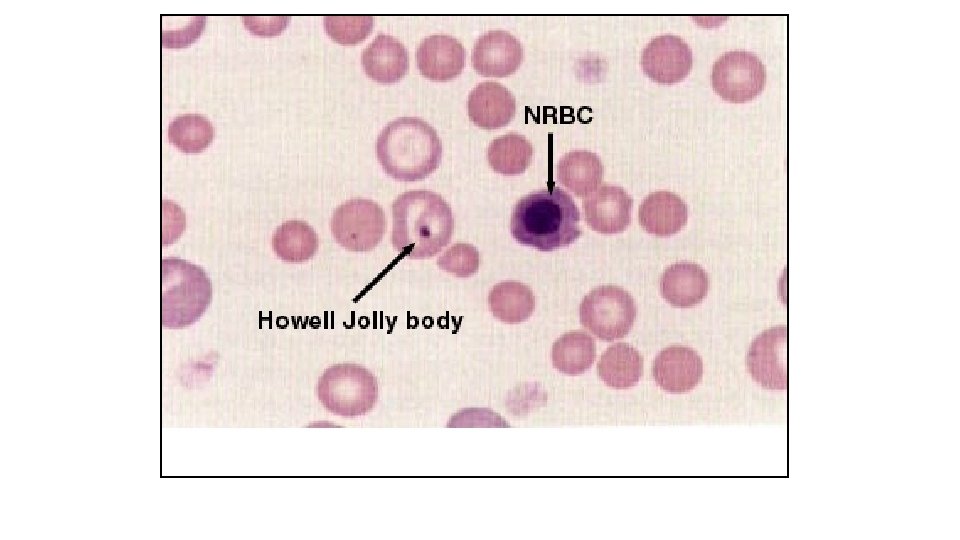

Erythrocyte Morphology Normal Morphology Size abnormalities Shape abnormalities

Erythrocyte Morphology Normal Morphology Size abnormalities Shape abnormalities Color abnormalities RBC Inclusions

Normal Erythrocyte Morphology • Most common of blood cells on a blood smear • Biconcave disc • No nuclei in mammal RBC’s • Nuclei present normally in bird and reptile blood • Normal canine RBC’s have a central pallor (lightness) to them


Erythrocytes on a Needle

RBC Size & Pigment • Normocytic • Macrocytic • Microcytic • Normochromic • Hypochromic • No such thing as “Hyperchromic” • Why?


Erythrocyte Size Abnormalities • Record abnormal findings under “General Comments” on the hemogram • Anisocytosis • Macrocytes • Microcytes • Normocytic



Erythrocyte Shape Abnormalities (Poikilocytosis) Schistocytes Acanthocytes Crenation (Echinocytes) Keratocytes Spherocytes Target Cells (Codocytes)

Erythrocyte Shape Abnormalities • Poikilocytosis – general term for shape abnormalities

Schistocytes • RBC fragments

Acanthocytes (Spur cells) • Unevenly distributed surface projections of different lengths


Crenation • Echinocytes (Burr cells) – spiculated (pointed) cells with short, evenly spaced surface projections • Artifact? – slow drying of blood films • Feline blood

Crenation (Echinocytes)

Keratocytes • Helmet cells – contain a vacuole?
Spherocytes • Darkly staining RBC’s with no central pallor Canine only? • Autoimmune hemolytic anemia
Target Cells (Codocytes) • RBCs with central rounded area of hemoglobin surrounded by clear zone • A few in normal blood? • Associated with anemias

Target Cells

Erythrocyte Color Abnormalities • Normochromic • Polychromasia – polychromatophilic RBCs • Blue tint to cytoplasm, due to presence of organelles remaining in cytoplasm (young cells) • Hypochromic – decreased staining due to insufficient hemoglobin in cells Hyperchromic (no such thing!)


RBC Inclusions Reticulocytes Basophilic Stippling Howell-Jolly Bodies Heinz Bodies Nucleated RBCs (NRBCs)

Reticulocytes • Immature RBCs that contain organelles (ribosomes) • As cell matures they are lost • Account for diffuse bluegray stain with Wright’s stain • 1% in normal circulation • Special stains needed usually


Basophilic Stippling • Presence of small, darkblue bodies all over RBC • Represents residual RNA • Common in immature RBCs


Howell-Jolly Bodies • Basophilic nuclear remnants • Seen in young RBCs in response to anemia • Phagocytes in spleen remove these remnants

Heinz Bodies • Rounded structures representing denatured hemoglobin • Pale or blue area, depending on stain • Cause: certain oxidants or drugs • Normal cats may have them

Heinz Bodies




Nucleated RBCs (NRBCs) • Also called metarubricytes • Represent early release of immature cells during anemia • If > than 5 per 100 WBC’s • Correct WBC Count • Normal in bird & reptile blood

NRBC’s – How Many Do You See?
- Slides: 39